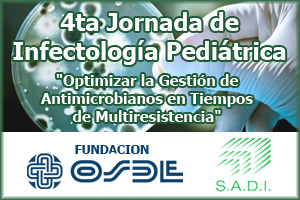

Jornadas de Microbiología y Genética. Organiza Carrera de Especialización en Bioquímica Clínica. 30 y 31 de Marzo de 2017 de 18 a 21hs. Sede: Colegio de Bioquímicos de Tucumán
La fundación OSDE Tucumán y su presidente el Dr. Juan Carlos Britos amablemente invita al Colegio de Bioquímicos de Tucumán y a todos sus sociosa participar de la video conferencia de las 4tas Jornadas de Infectología Pediátrica organizada por la Sociedad Argentina de Infectología, en el marco de «Optimizar la Gestión de Antimicrobianos en Tiempos de Multiresistencia».

La SLAGF organiza cada año las Jornadas Latinoamericanas de Genética Forense, como un foro donde se expone la situación actual de cada uno de los países miembros y avances mundiales en el área de la Genética Forense. En el año 2016 las VII Jornadas se realizaran en Santo Domingo, República Dominicana.

Brindar capacitación y actualización teórica y entrenamiento práctico al personal técnico y auxiliar de los laboratorios, en temas relacionados a su práctica diaria, a fin de asegurar la calidad de atención, optimizar los procesos y lograr la satisfacción de pacientes y demás profesionales de la salud.